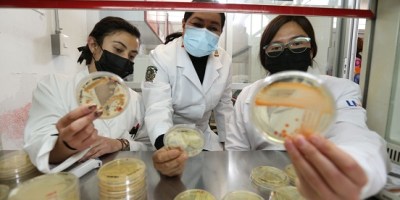

Empresarial, Información de los Estados, Presidencia de la República

Entradas 39

Empresarial, Información de los Estados, Presidencia de la República


Información de los Estados, Justicia






Aeropuertos, Estado de México, Política

INE, Información Nacional, SEGOB



Dependencias Gubernamentales, Información Nacional, Justicia

Espectáculos, Información Internacional, Justicia

Información de los Estados, seguridad, Seguridad Pública


Información Nacional, Presidencia de la República, Ricardo Monreal, Senado de la República

CDMX, Información Nacional, seguridad, Seguridad Pública

Deportes, Información Internacional

Deportes, Información Internacional, Justicia


Aeropuertos, CDMX, seguridad, Seguridad Pública

Guardia Nacional, Información de los Estados, seguridad, Seguridad Pública


Información Nacional, Política




Aeropuertos, Estado de México, Información Nacional, Presidencia de la República

Dependencias Gubernamentales, Información Nacional, Presidencia de la República

Información Nacional, Presidencia de la República, Turismo

Educativas, Estado de México, UAEM, UAEMéx